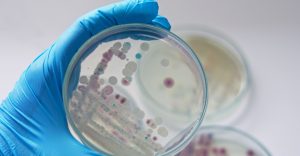

Om du ofta får hål i tänderna, lider av sömnbrist eller känner en stickande känsla i benen kan det vara ett tecken på att du saknar något viktigt i din kost.
Som barn får vi i oss mycket mjölk – först från vår mamma, sedan till frukost, och många minns säkert också skolmjölken.
Men i takt med att vi blir äldre hamnar mjölken mest i kaffet, i små eller stora mängder, och det kan faktiskt märkas på kroppen.
Många vuxna lider av kalciumbrist, vilket kan få allvarliga konsekvenser. I värsta fall kan långvarig brist öka risken för benskörhet (osteoporos), skriver dagens.no.
Därför är det viktigt att vara uppmärksam på dessa symtom:
1. Kramper och stickningar i benen
Brist på kalcium kan leda till spasmer i nervändarna och ge en stickande känsla i musklerna. Vaknar du på natten med kramp eller domningar i lår och vader kan det bero på kalciumbrist.
2. Hål i tänderna och sköra naglar
Om tandläkaren ofta hittar hål är det inte alltid colan eller chokladen som är boven. Dåliga tänder kan i stället vara ett tecken på kalciumbrist. Sköra, mjuka naglar med vita fläckar kan också tyda på det. När kroppen saknar kalcium tar den det från andra källor – som tänder och naglar – vilket gör dem svagare.
3. Sömnproblem och stelhet
Kalcium behövs för att producera sömnhormonet melatonin. Halterna stiger när du faller i djupsömn. Svårigheter att somna kan därför vara en varningssignal. Om du dessutom vaknar stel i nacke eller rygg kan även det tyda på brist.
4. Minnesproblem och kramper
I mer allvarliga fall kan kalciumbrist orsaka minnesförlust, hallucinationer och till och med krampanfall.
Ett varierat och näringsrikt kosthåll med mejeriprodukter som mjölk och lagrad ost är ett bra sätt att ge kroppen tillräckligt med kalcium. Det går också att ta tillskott vid behov.
Om du känner igen några av dessa symtom bör du kontakta läkare för att få rätt behandling.
Ett extra glas mjölk på kvällen räcker alltså inte.